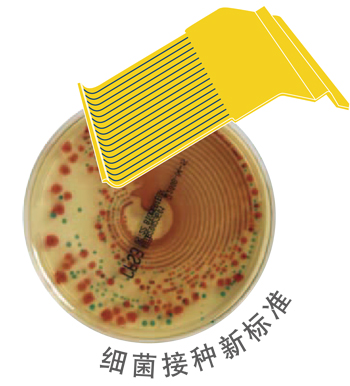

PREVIIsolaTM全自動平板接種儀是一種用于劃線接種成品培養基的革命性自動化系統。
全自動、標準化的平板接種系統,取代了繁瑣而重復的分析前樣本處理步驟,解放了微生物學家,可以從事更高附加值的工作。
生物梅里埃致力于實現分析前樣本處理過程自動化,加快微生物實驗室的工作流程,并使之標準化。
![]()
顯著提高細菌分離能力單個菌落數量比傳統劃線接種提高44%
實現常規操作標準化,提高結果重復性、可比性
定量接種標本可進行半定量菌落計數
優化現有微生物實驗室工作流程
![]()
革命性的工作效率每小時可接種180塊平板
6個標本架位置一次可同時處理多達114份標本
5個上樣平板架,3個完成平板架
| 傳統四區劃線接種 | 革命性的接種涂布器 | 自動化接種方法 |
![]() |
![]() |
![]() |

相當于17個接種環并排使用
精確地環形旋轉接種.更快、更簡便地判讀結果
更有效利用平板接種面積獲取更多單個菌落
超聲傳感器探測瓊脂表面高度優化接種角度精確控制接
種器接種壓力
接種器、吸頭一次性使用避免交叉污染
減少接觸感染性標本提高生物安全性

可同時接種各種臨床常見標本如尿、糞、痰、體液、拭子等
不同種類標本采用不同接種體積、接種器轉速
提供多種尺寸標本管架可同時處理各種不同標本
可同時使用直徑90-94mm常規平板及二分平板
![]()
人性化軟件圖形化操作界面
全自動系統只需輸入標本信息
上樣后即不再需要人工介入
觸摸屏操作,最少信息輸入
可連接LIS系統直接導入病人、標本信息
自動打印條碼標記每塊平板保證數據可追溯性
智能化系統可根據標本類型自動分配接種流程
接種完成平板可根據培養條件分類
1、全自動平板接種儀ISOLA:對于使用了100多年的傳統方法,ISOLA的誕生使細菌接種進入了一個全新的自動化時代,并獲得了“2010年醫療儀器設計優秀獎“;
2、獨創的接種涂布器相當于17個接種環同時并手柞使用,有效的利用平板接種面積旋轉330度,單個菌落數量分離提高44%;
3、接種涂布器、吸頭均為一次性使用,從而避免了交叉污染;
4、可同時處理6種不同的標本,一次最多處理114份標本,過程中不需要切換程序,可直接接種臨床常見標本,如尿、糞、痰、拭子等;
5、1小時可完成180塊平板接種的高通呈平臺;
6、可以隨時裝載新平板,隨時卸載已完成的平板;
7、可直接觸屏操作,操作更加簡單方便;
8、儀器可自動打印每塊平板的條碼標記從而保證數據的可溯性;
9、可連接LIS系統,直接導入病人與標本信息;
10、全自動化儀器,提高了結果的重復性、可比性、以及實驗室的生物安全性;并優化了現有實驗室的工作流程。

![]()
鄭州飛龍醫療設備有限公司
【飛龍醫療業務咨詢熱線】:400-992-8768
【辦公電話】:0371-67896619
【電子郵件】:feilongyiliao@163.com
【公司網址】:www.www.powerwms.com
【聯系地址】:河南省鄭州市高新技術產業開發區梧桐街32號漢威物聯網科技產業園8號樓1層、2層、4層、5層
【郵政編碼】:450001
| * 聯系人: | 請填寫您的真實姓名 |
| * 手機號碼: | 請填寫您的聯系電話 |
| 電子郵件: | |
| * 采購意向描述: | |
| 請填寫采購的產品數量和產品描述,方便我們進行統一備貨。 | |
| *驗證碼: |
|
| 我要評論: | |
| 內 容: |
(內容最多500個漢字,1000個字符) |
| 驗證碼: | 看不清?! |
辦公電話:0371-67896619
地址:河南省鄭州市高新技術產業開發區梧桐街32號漢威物聯網科技產業園8號樓1層、2層、4層、5層
共有-條評論【我要評論】